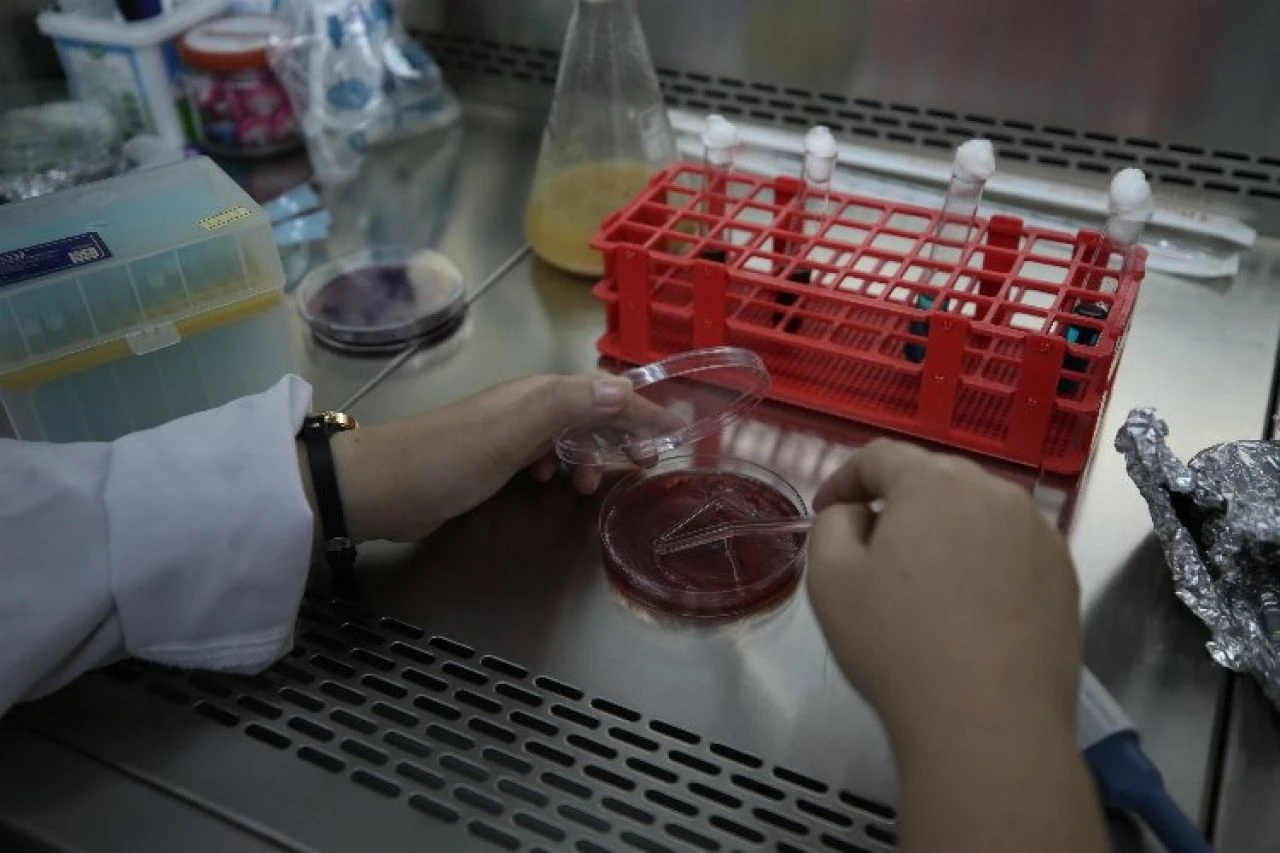
Ezine peyniri yapay zekaya emanet... Sahteciliğin önüne geçilecek! - 1. Resim

Kategoriler
UYGULAMALAR
İstanbul

TÜBİTAK destekli bu projede, Ezine peyniri üretiminde kullanılan süt toplama merkezlerinin ve üretim süreçlerinin coğrafi koordinatları veri tabanına kaydediliyor. Belirlenen bölgeler dışından ham madde temini ve işaretli imalathaneler dışında üretim yapılması halinde uyarılar veriliyor.
Projeyi yürüten ekip, Ezine peynirinin uluslararası marka değerinin korunmasına ve sahteciliğin önlenmesine katkı sağlamayı hedefliyor.
ÇOMÜ Rektörü Prof. Dr. Cüneyt Erenoğlu başkanlığında devam eden yapay zeka destekli çalışmalar kapsamında Bilgisayar Mühendisliği Bölümünden Dr. Öğretim Üyesi Enis Arslan'ın yürütücülüğünde Ezine Gıda İhtisas OSB Meslek Yüksekokulu Gıda İşleme Bölümünden Dr. Öğretim Üyesi Dilvin İpek'in araştırmacı olarak yer aldığı proje hayata geçirildi.
Türkiye Bilimsel ve Teknolojik Araştırma Kurumu (TÜBİTAK) destekli "Coğrafi İşaretli Ürünlerde Coğrafi İşaret İhlali ve Hileli Standart Dışı Ürün Tespiti İçin Akıllı Takip Yazılımı Geliştirilmesi Projesi" kapsamında hazırlanarak testleri başarıyla tamamlanan yapay zeka destekli yazılım sistemi için Türk Patent ve Marka Kurumundan patent alındı.
Yazılımın veri tabanına, coğrafi sınırları Ezine, Bayramiç, Ayvacık ilçeleri, Çan ilçesine bağlı Şerbetli, Etili, Ahlatlıburun, Küçüklü, Alibeyköy ve Söğütalan köyleri, merkez ilçeye bağlı Karacaören, Kurşunlu, Şerbetli ve Kirazlı köylerinde yer alan süt toplama merkezleri ve Ezine peyniri imalathaneleri işlendi.
Üniversitede ve üreticilerde bulunacak yazılım, veri tabanına işlenmiş süt toplanan yerleşim birimlerinden başka yerlerden ham madde temin edilmesi, işaretli imalathaneler dışında üretim yapılması halinde uyarıda bulunuyor, ayrıca imalat aşamasında yağ oranı ve diğer bileşenler hakkında bilgi veriyor.
Ezine peynirinin uluslararası marka değerinin korunmasına yönelik hazırlanan sistemin, ÇOMÜ bünyesinde kurulacak analiz merkezinde kullanımına başlanması hedefleniyor.

Prof. Dr. Erenoğlu, yaptığı açıklamada, gerek Çanakkale gerekse Türkiye ölçeğinde çok önemli bir marka olan Ezine peynirinin geleceğine katkı sunacak yazılım geliştirmenin mutluluğunu yaşadıklarını söyledi. Bölgede çok sayıda coğrafi işaretli gıda ürünü bulunduğunu belirten Erenoğlu, coğrafi işaret ve tescilin, o ürünün ve üretildiği tesisin garantisi anlamına geldiğini belirtti.
Bu projede tescillenen ürünlerin süreç içinde ilk imalattan tüketime kadar olan süreci, bir yerde gıda kodeksi gibi teminat altına aldıkları bilgisini paylaşan Erenoğlu, şöyle konuştu:
"Ezine peyniri popüler bir konu. Bölgemizde sütün üretilmesinden toplanmasına, mayalanmasına ve paketlenmesine kadar olan süreçler coğrafi işaretli ürünün tescilinin kontrolünü sağlıyor. Proje kapsamında uygulama aşamasında mandıra ölçeğine giderek mandıradan, toplama merkezlerinden toplanan ürünlerin coğrafi bilgi sistemleri ve küresel konumlama sistemleri bazlı koordinatlarını aldık. Sonra bu koordinatları bir veri tabanına topladık. Her bir üreticiyi aslında Bayramiç, Ezine ve merkez ilçe bazında coğrafi olarak tescillemiş olduk."
Erenoğlu, süt toplama merkezlerinden üretime kadar uzanan süreçte sistemin ve prosesin kontrolünü sağladıklarını dile getirdi. Projeyle, Ezine peynirinin korunmasına katkıda bulunmayı amaçladıklarını aktaran Erenoğlu, "Bundan sonra yapılacak iş, kalite ve standardizasyonu koruyarak uluslararası anlamda marketing, pazarlama, fuar gibi stratejilerini gerçekleştirmek." dedi.
Dr. Öğretim Üyesi Enis Arslan da projenin "1005 Ulusal Yeni Fikirler ve Ürünler Araştırma Destek Programı" kapsamında TÜBİTAK tarafından desteklendiğini bildirdi. Projenin 18 aylık süreci kapsadığını kaydeden Arslan, önemli sayıda bursiyerden oluşan bir ekibin görev aldığı çalışmalarının genel olarak Ezine peynirini hedef alan bir proje olduğunu, proje sürecinde önemli bir üretici firma tarafından desteklendiklerini anlattı.
TÜBİTAK'ın da kendilerine gerekli ekipman ve finansman desteğini sağladığını vurgulayan Arslan, "Bu proje Ezine peyniri sürecine özel olarak geliştirildi ama modüler bir yapıda olması sebebiyle farklı alanlarda da kullanılabilir. Peynirin kalitesinin artırılmasına yönelik önemli bir proje." diye konuştu.
Arslan, özellikle gıda sahteciliğine karşı bazı parametrelerle kimyasal analizler üzerinden yapay zeka algoritmalarının kullanılmasının öne çıktığını anlattı.
ÇOMÜ Yeşil Dönüşüm Koordinatörü Dr. Öğretim Üyesi Dilvin İpek ise temelde projenin, geliştirdikleri yazılım sayesinde üretim sırasında coğrafi işaretli ürün hatalı ise geri dönüşünün sağlandığını, piyasaya sunulması engellendiği için ciddi ekonomik kaybın önüne geçilebileceğini belirtti.
Ayrıca, yazılımın piyasada bulunan coğrafi işaretli ürünlerin belirtilen özelliklere sahip olup olmadığının tespitine de yardımcı olduğu bilgisini veren İpek, şunları kaydetti:
"Projede özellikle kalite parmak izini araştırma konusunda çalıştım. Burada kalite parmak izini araştırırken zaten ürünlerin menşe belgelerinde onunla ilgili bazı kalite parametreleri oluyor; protein ve yağ gibi. Ezine peyniri uluslararası tanınmış bir coğrafi işarete sahip. Ezine peynirini bu anlamda koruma altına aldık. Ezine peynirinin proses sırasında, üretim sırasında hangi değerlere sahip olması gerektiğini biliyoruz ve bunu üretim sırasında karşılaştırıp görebiliyoruz. Bu yazılım sayesinde piyasadaki ürünlerin de gerçekten Ezine peyniri olup olmadığını anlayabiliyoruz. Biz bu dijital istasyonu Ezine peynirinin içine yerleştirerek hem takibinin kolaylaşmasını hem de tüketiciyi yanıltıcı ürünlerin tespit edilebilmesini sağladık. Bu hem tüketiciyi hem de üreticiyi korumayı sağlıyor. Çünkü Ezine peyniri gibi coğrafi işaretli ürünlerde hem üreticinin hem de ham madde üreticisinin aynı coğrafi alanda olması gerekiyor. Dolayısıyla bir yöre için çok önemli. Ekonomik anlamda çok değerli bir ürün. Bunun başka bir yerde üretilmesi çok büyük bir ekonomik kayıp demek."